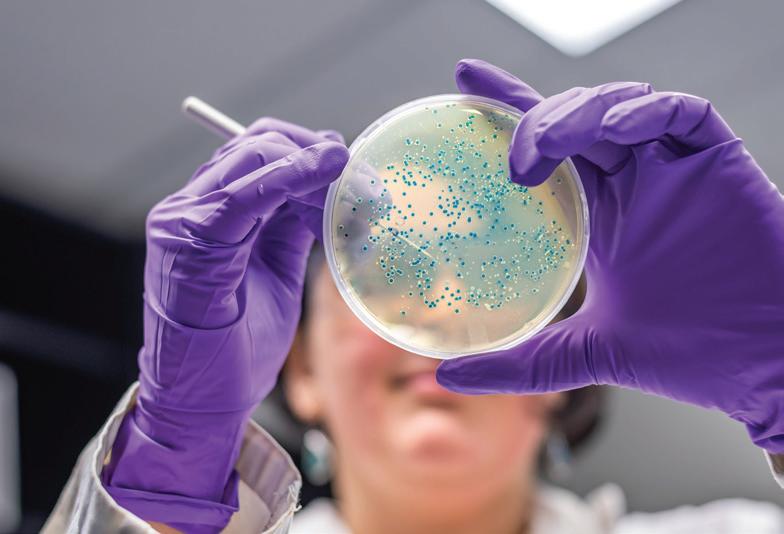

Sustainability at the Wyss
Pam Silver, Ph.D. Wyss Institute Core FacultyIgrew up in Silicon Valley in the 1960s, before it was dominated by tech companies’ campuses. It was beautiful: fruit orchards, forests, the Pacific Ocean just next door. Now, having lived on the East Coast for decades, I get my Nature fix by sailing on the Atlantic and paddleboarding on Walden Pond. But one day last summer when I arrived at the pond for my afternoon paddle, I saw a sign tacked to a tree at the beach with a big red X though images of fish on it. The sign said that the water in Walden Pond is now contaminated with PFAS, or “forever chemicals,” and consuming the fish is unsafe.
I have dedicated much of my scientific career to exploring how we can engineer life itself to solve problems through the discipline of synthetic biology. Living organisms have many advantages over nonliving machines: they are resilient and flexible, they can self-heal, and they can interact with other living systems, including the human body. Members of my lab have engineered bacteria that can detect and report diseases in the human gut, produce valuable feedstock materials, and communicate with each other to work together to improve human health.
We are now using the power of synthetic biology to address the climate crisis. It has become clear that exploiting Nature for short-term gain is what got humanity into this mess. We need to work with Nature to remediate current issues and find new, sustainable alternatives to fossil fuels, synthetic materials, and more.
Not only that, we have to ensure that these ideas work outside the lab and can be deployed equitably throughout the world. The Wyss Institute’s innovation engine has delivered groundbreaking technologies and products to the market in record time; I’m committed to getting more sustainability solutions into that pipeline so they can be developed, de-risked, and commercialized, fast.

GET INVOLVED
The Wyss Institute is a “dream space” unlike any other, where we harness the creative power of our world-class scientists, engineers, and clinicians to change the world. But our breakthrough discoveries can’t change the world if they don’t leave the lab. We are always seeking partners who share our vision of addressing global challenges in healthcare and the environment through innovative science. Whether you’re interested in investing in our startups, supporting our next moonshot idea through philanthropy, or bringing us a problem to solve, we’d love to connect with you. Get in touch today to learn how you can get involved.
I’m incredibly energized by the passion and creativity of the next generation of scientists and engineers I work with at the Wyss Institute. My colleagues Jennifer Lewis and Jim Collins are also leading the charge, bringing their labs’ unique expertise to bear on this existential problem. The climate crisis is too big for any one person to solve, but by working together, we stand a chance at restoring our Earth to the beautiful place it was when I was growing up.
Please join us in our mission to make the world more sustainable using the power of biology.
Warmly,
Bob Cunningham
Senior Director of Strategic Engagement
robert.cunningham@wyss.harvard.edu
Jonelle Prill-Tate
Associate Director of Strategic Engagement
jonelle.prill-tate@wyss.harvard.edu


Our Sustainable Future Watch how we are developing sustainable materials and devices to ensure a bright future and a healthy planet for future generations to inherit.

Solving Sustainability with SYNTHETIC BIOLOGY
HOW HARNESSING THE POWER OF MICROBES
COULD SAVE US ALL

As humans, we like to think that we are the smartest animals on planet Earth. After all, no other species has invented smartphones, heat pumps, or jet engines. But for all our innovations, we have also created problems on a global scale.
Take plastic, for example.
Humans now produce more than 350 million metric tons of plastic waste per year. That’s the equivalent of 10 million fully loaded garbage trucks. While we have acknowledged that plastic pollution is a problem we need to solve, so far, humans have failed to find a viable solution.
Microbes, on the other hand, have developed a very simple one in the same timeframe: just eat it.
Scientists have identified about 400 species of fungi and bacteria worldwide that have developed the ability to eat plastic. While this is exciting, microbes aren’t very good at eating plastic yet - studies
estimate that they can only digest about 1% of the plastic they encounter every year.
Fortunately, we don’t have to wait for Nature to speed up this process: we can accelerate it with synthetic biology.
How
do we make an Earth
that is safe and comfortable for the more than 10 billion people who
are going to live here? The engineering of biology is the technology of this century, and we envision a world where microbes are the key.
Pam Silver Wyss Core FacultyThe Wyss Institute at Harvard University was founded on the principle of biologically inspired engineering: looking to Nature as the source of insights and solutions to pressing problems. Synthetic biology – the engineering of living organisms to achieve certain goals – is a cornerstone of the our sustainability work across four main focus areas: Materials, Remediation, Food and Water, and Resilience.
It has taken Nature millions of years to evolve microbes that perform a host of critical functions, from digesting food in the human gut to breaking down detritus into useful molecules for other creatures. We can evolve microbes in the lab in a matter of weeks – unlocking a treasure trove of previously untapped opportunities.
We then leverage our Wyss innovation pipeline, a unique model of technology development and de-risking that we have developed and used to successfully launch impactful products and companies over the last 15 years, to accelerate these solutions to the market.
Read more about how we’re using synthetic biology to address the climate crisis. And for a deeper dive, check out this recent review written by Wyss Core Faculty member Pam Silver.
We know we cannot fix the planet’s problems alone, and are always looking for like-minded people and organizations who want to help galvanize progress in this critical area. If you’re interested, reach out to us to get involved. The future of humanity depends on it.

From Montreal to a menu near you
Wyss Lumineer Luke MacQueen’s journey from chasing a dream to running a company
In 2011, Luke MacQueen was a graduate student at Polytechnique Montréal harboring a secret fantasy: growing meat to feed the planet without harming animals. He saw a chance to bring his sci-fi dream to life in the form of a poster for an event that was being hosted more than 250 miles away: the 2011 Wyss Symposium. It offered him the opportunity to meet many scientists whose work he admired, so he booked a bus ticket and made the seven-hour journey from Montreal to Boston.
He had no idea that this trip would change the course of his life.
There was a huge, huge opportunity in plant-based meats, because up until then no company had solved the texture problem. We decided the time was right to start a company that could use our spunfiber technology to make animal-free meat taste and feel like the real thing.
Luke MacQueen
Co-Founder, Tender Food


Two years later, MacQueen was interviewing for a postdoc position with Wyss Associate Faculty member Kit Parker, whose lab engineers living tissues. He posed the question that had been burning in the back of his brain for years: “What if we could just grow meat?” Rather than ridiculing him, Parker – a self-professed meat lover – got excited, and they had a full dicussion about the possibilities and challenges. “It completely sold me on moving down here and starting this type of research,” says MacQueen.
MacQueen started working in Parker’s lab in 2013, where he met Christophe Chantre and Grant Gonzalez, both graduate students at the time. The three of them realized that a “hightech cotton candy machine” that Gonzalez had recently invented could turn almost anything into a fiber - and, since meat is composed of muscle fibers, it could be the answer to MacQueen’s question. Seven years of hard work later, the three of them launched Tender Food from the Wyss Institute to commercialize their technology and bring better meat alternatives to the market.
Read more about Luke’s journey and how Tender Food aims to reduce greenhouse gas emissions from food production.
Emily Stoler on Developing Sustainable Solutions
When Emily Stoler was eighteen years old, she described her aspirations to a taxi driver – using her science knowledge to build a more sustainable future. Now, after studying chemistry and working across academia and industry, she finally has the role she envisioned as the Principal Scientist in Sustainable Materials at the Wyss Institute.
Stoler is taking stock of where the Wyss’ strengths lie – materials, food and water, remediation, and resilience – and discovering how we can improve our capacity for eco-friendly projects. She’s building up the Institute’s Sustainability Initiative by making connections and collaborating across disciplines with the goal of more quickly translating green technology out of the lab to mitigate climate change.
“Industry has money for research and development, but their need to make a profit limits their ability to take risks. In traditional academia, there are many innovative solutions that aren’t getting out. Since the Wyss sits at the crossroads between the two, working here gives me the opportunity to use my understanding of how companies think to translate some of those ideas into real-world products more rapidly, ultimately improving the health of our planet.”
Read the full story on our website.


WHAT’S HAPPENING IN SUSTAINABILITY
Both in our labs and out in the real world, Wyss research teams and startup companies are working to solve a variety of problems to help address the climate crisis and make our planet sustainable for future generations.
Materials | Making stuff
without using fossil fuels
The Aizenberg lab is exploring natural sources of super-water-repellent fabrics to replace PFAS.
The Lewis and Bechthold labs are creating a home insulation material made from algae foam.
The Ingber lab is using Shrilk, a material derived from shrimp shells, to make biodegradable plastic.
“The Future Is Now: Pioneering the Sustainable Materials Revolution“ – An overview of the opportunities in sustainable materials that the Wyss and Collab Fund are exploring.
Food and Water | Ensuring what we eat helps us and the planet
The Silver lab is investigating intrinsically disordered proteins derived from water bears to protect crops from droughts.
The Ingber lab is applying a compound that can put living organisms into “biostasis” to slow the ripening process and reduce food waste.
The Silver, Church, and Collins labs are creating the next generation of alternative proteins that are derived from microbes.
“Are microbes the future of fertilizer?” – An article in Forbes about Wyss startup Kula Bio.
Remediation | Cleaning up the mess we’ve made
The Collins lab is creating enzymes that can break down PET (#2 plastic) to create a biopolymer feedstock and decarbonize plastic.
The Ingber lab is developing low-cost microchip biosensors that can monitor the environment for health hazards.
“One solution to the plastic crisis may lie in bugs’ bellies” – An article in the Washington Post about our microbebased plastic degradation technology. It’s now being developed by Wyss startup Breaking, which has raised a $10.5M seed round. This “Breaking” news was reported by the Boston Business Journal.
Resilience | Weathering the worst effects of climate change
The Aizenberg lab has created a novel air conditioning technology that cools and dehumidifies air without the use of refrigerant chemicals. According to Scientific American, this technology could be the future of cool.
The Collins lab is developing a monitoring system that can detect and report dangerous red tide blooms quickly.
The Ingber lab has created a device called Aquapulse that sterilizes water without the use of expensive filters that are prone to clogging.

Reimagining Sustainability at the Wyss Institute
In March, the Wyss Institute and Collaborative Fund co-hosted an event celebrating our venture alliance to bridge the ‘valley of death’ and drive innovation in sustainable materials. The attendees included founders of several startups in the sustainability space, including Wyss spin-outs Kula Bio, Circe Bioscience, and Tender Food, and collaborators and friends from VC and industry.



Wyss Institute at Harvard University
201 Brookline Ave., Boston, MA 02215 wyss.harvard.edu

The presenters included Wyss Founding Director Don Ingber; Wyss Technology Translation Director and COO Angelika Fretzen; Wyss Core Faculty member Pam Silver; Wyss Principal Scientist in Sustainable Materials Emily Stoler; Collab Fund Partner Sophie Bakalar; and Former Chief Sustainability Officer of Nike Noel Kinder. After the presentations and panel discussions, guests got to enjoy the fruits of the Wyss’ labors by viewing Circe’s chocolates made with cocoa butter derived from microbes and tasting Tender Food’s meat-free chicken cutlets and pulled pork made from spun plant fibers.

